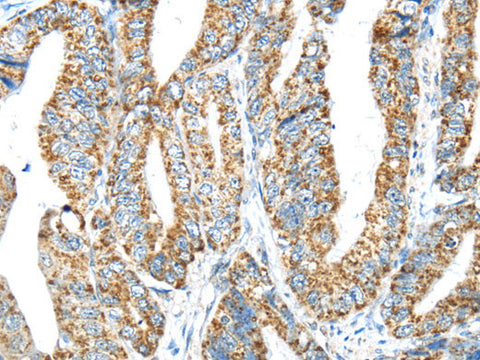
IFNA2 Polyclonal Antibody Store at -20°C
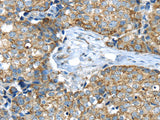
IFNA2 Polyclonal Antibody Store at -20°C

IFNA2 Polyclonal Antibody Store at -20°C
SKU: E-AB-13320-200
IFNA2 Polyclonal Antibody Store at -20°C
| SKU # | E-AB-13320 |
| Reactivity | Human |
| Host | Rabbit |
| Applications | IHC |
Product Details
| Isotype | IgG |
| Host | Rabbit |
| Reactivity | Human |
| Applications | IHC |
| Clonality | Polyclonal |
| Immunogen | Synthetic peptide of human IFNA2 |
| Abbre | IFNA2 |
| Synonyms | Alpha 2a interferon, IFN alpha 2b, IFN-alpha-2, IFNA, IFNA2, INFA2, Ifna2, Interferon alpha 2, Interferon alpha A, Interferon alpha-2, Interferon alpha-A, LeIF A, LeIFA |
| Swissprot | |
| Cellular Localization | Secreted. |
| Concentration | 0.5 mg/mL |
| Buffer | Phosphate buffered solution, pH 7.4, containing 0.05% stabilizer and 50% glycerol. |
| Purification Method | Affinity purification |
| Research Areas | Cancer, Immunology |
| Conjugation | Unconjugated |
| Storage | Store at -20°C Valid for 12 months. Avoid freeze / thaw cycles. |
| Shipping | The product is shipped with ice pack, upon receipt, store it immediately at the temperature recommended. |
Related Reagents
| Applications | Recommended Dilution |
| IHC | 1:50-1:200 |
Background
This gene is a member of the alpha interferon gene cluster on chromosome 9. The encoded protein is a cytokine produced in response to viral infection. Use of the recombinant form of this protein has been shown to be effective in reducing the symptoms and duration of the common cold.